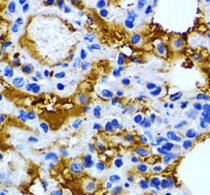

ARG41007
anti-pS2 / Trefoil factor 1 antibody
anti-pS2 / Trefoil factor 1 antibody for IHC-Formalin-fixed paraffin-embedded sections,Western blot and Human,Mouse,Rat
Overview
| Product Description | Rabbit Polyclonal antibody recognizes pS2 / Trefoil factor 1 |
|---|---|
| Tested Reactivity | Hu, Ms, Rat |
| Tested Application | IHC-P, WB |
| Host | Rabbit |
| Clonality | Polyclonal |
| Isotype | IgG |
| Target Name | pS2 / Trefoil factor 1 |
| Antigen Species | Human |
| Immunogen | Recombinant fusion protein corresponding to aa. 25-84 of Human pS2 / Trefoil factor 1 (NP_003216.1). |
| Conjugation | Un-conjugated |
| Alternate Names | D21S21; pNR-2; Trefoil factor 1; PNR-2; BCEI; hP1.A; HPS2; pS2; Polypeptide P1.A; HP1.A; Protein pS2; Breast cancer estrogen-inducible protein |
Application Instructions
| Application Suggestion |
|
||||||
|---|---|---|---|---|---|---|---|
| Application Note | * The dilutions indicate recommended starting dilutions and the optimal dilutions or concentrations should be determined by the scientist. |
Properties
| Form | Liquid |
|---|---|
| Purification | Affinity purified. |
| Buffer | PBS (pH 7.3), 0.02% Sodium azide and 50% Glycerol. |
| Preservative | 0.02% Sodium azide |
| Stabilizer | 50% Glycerol |
| Storage Instruction | For continuous use, store undiluted antibody at 2-8°C for up to a week. For long-term storage, aliquot and store at -20°C. Storage in frost free freezers is not recommended. Avoid repeated freeze/thaw cycles. Suggest spin the vial prior to opening. The antibody solution should be gently mixed before use. |
| Note | For laboratory research only, not for drug, diagnostic or other use. |
Bioinformation
| Database Links | |
|---|---|
| Gene Symbol | TFF1 |
| Gene Full Name | trefoil factor 1 |
| Background | Members of the trefoil family are characterized by having at least one copy of the trefoil motif, a 40-amino acid domain that contains three conserved disulfides. They are stable secretory proteins expressed in gastrointestinal mucosa. Their functions are not defined, but they may protect the mucosa from insults, stabilize the mucus layer, and affect healing of the epithelium. This gene, which is expressed in the gastric mucosa, has also been studied because of its expression in human tumors. This gene and two other related trefoil family member genes are found in a cluster on chromosome 21. [provided by RefSeq, Jul 2008] |
| Function | Stabilizer of the mucous gel overlying the gastrointestinal mucosa that provides a physical barrier against various noxious agents. May inhibit the growth of calcium oxalate crystals in urine. [UniProt] |
| Cellular Localization | Secreted. [UniProt] |
| Calculated MW | 9 kDa |
Images (1) Click the Picture to Zoom In